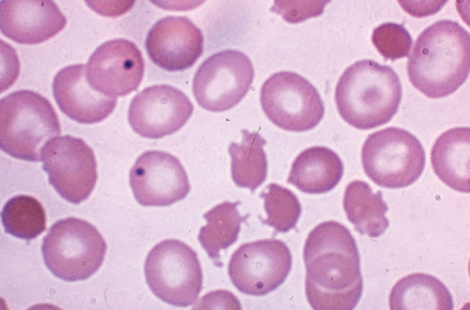

What is a common presentation of malabsorption?
Weight loss and diarrhoea in someone with a normal diet
When should Coeliac disease be suspected?
Pathology of coeliac disease?
Describe the presentation of coeliac?
Describe the diagnosis of coeliac disease?
Describe the treatment for coeliac?
Describe some complications of coeliac disease?
What signifies fat malabsorption?
What are the three processes that can lead to malabsorption?
Describe intraluminal maldigestion?
Describe mucosal malabsorption?
Describe Post-mucosal lymphatic obstruction?
Draw a flowchart for the investigations into malabsorption

Name some other causes of malabsorption?
What are the blood features of hyposplenism?
Name some other causes of subtotal villous atrophy?
How can malabsorption cause hyposplenism?
Chronic folate deficiency
What is pictured here?
